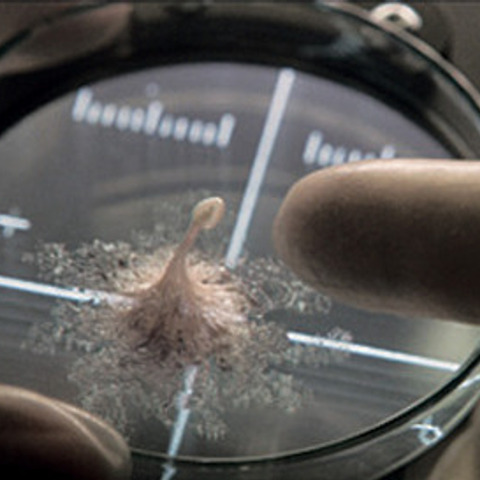

공포의 탈을 쓴 코미디 드라마 '해피데스데이' 감상문

공포의 탈을 쓴 코미디 드라마 '해피데스데이' 감상문
반응형
Today is the first day of the rest of your life.
오늘은 너의 남은 인생의 첫 날이다.
 |  |  |
(주연) 제시카 로테
#01 내용 요약
생일날 반복된 죽음을 경험하는 여대생의 기묘한 이야기.
평소 싸가지없는 태도로 주변사람들로부터 미움을 받지만 핫한 외모덕에 인기는 늘 최고인 주인공 트리. 생일날 예정된 파티에 가다 가면을 쓴 누군가에게 살해 당하는 것을 계속 반복하게 되면서 점점 범인을 찾아 가게 되는 스토리.
예전에 언듯 본듯한 시나리오이긴 한데.......
#02 영화 감상평
공포인줄 알고 잔뜩 겁먹었는데 보다보니 공포영화의 긴장감은 유지되지만 코미디 요소가 적절히 섞여서 오히려 웃으면서 봤다. 주인공이 정말 예쁘다.
토끼를 닮은 듯한 가면이 묘한 공포감을 주며, 범인이 누군지 궁금하게 만든다.
해픈 여자였던 트리를 이끌어준 찌질이 남주인공, 그의 조언은 허접했지만 효과는 굉장했다.
반응형
'WRITE > 영화를말하다' 카테고리의 다른 글
| 4DX 로 안보면 후회할 영화 "레디 플레이어 원" (0) | 2018.04.01 |
|---|---|
| 영화 '개들의 전쟁' 후기 (0) | 2018.02.11 |
| 화성에서 시작 된 종말 <라이프 Life> 리뷰 (1) | 2017.10.15 |
| 이병헌이 선택한 영화, <싱글라이더> 리뷰 (0) | 2017.10.09 |
| 억울했던 10년간의 옥살이, <재심> 후기 (0) | 2017.04.03 |

글에 남긴 여러분의 의견은 개 입니다.